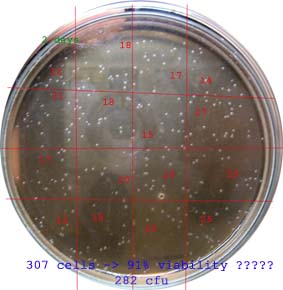
http://www.humle.se/punbb/images/upload/cfu-count.jpg

God Jull allihopa!!
Jag fick en oväntad "present" idag, jag har kört med methylenblått hittils men skulle försöka korrelera detta med odlingar, och kolonierna på min platt odling uppenbarade sig imorse!  Resultatet var ganska otippat som gett mig ytterligare en anledning att göra mer tester av jästlagring. De små liven tycks överleva längre än jag trodde och jag begriper inte hur. Jag har så svårt att svälja resultaten att ska göra mer testar innan jag vågar tro på det. Men om det verkligen stämmer skulle man kunna lagra jäst under många många år, utan risk för selektion.
Resultatet var ganska otippat som gett mig ytterligare en anledning att göra mer tester av jästlagring. De små liven tycks överleva längre än jag trodde och jag begriper inte hur. Jag har så svårt att svälja resultaten att ska göra mer testar innan jag vågar tro på det. Men om det verkligen stämmer skulle man kunna lagra jäst under många många år, utan risk för selektion.
Både min plattodling och methylenblått indikerade att 80-90% av cellerna levde i ett 19 månader kylförvarat Wyeast pack. Normalt skulle jag säga att det är helt orimligt!! jag har fortfarande svårt att tro på resultatet och jag leter efter "fel" jag kan ha gjort.... men jag ska göra lite mer tester och se, oväntade mysterier gör det hela roligare... 

/Fredrik